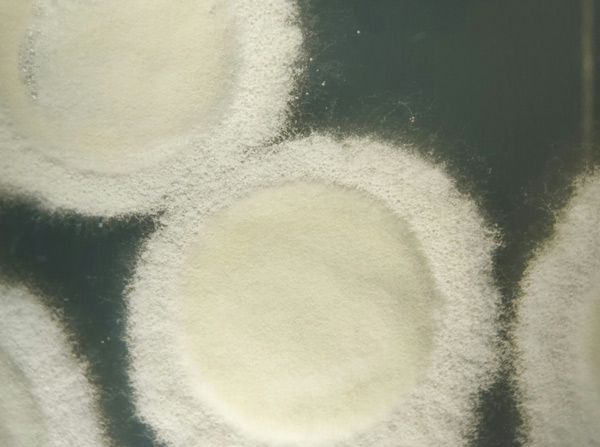

Resultados
Modo de ação
A infecção por Bovéria-Turbo® WP ocorre principalmente via tegumento do inseto. A germinação ocorre entre 12 a 18 horas após o contato, utilizando nutrientes como glucose, quitina e nitrogênio disponíveis no hospedeiro.
A penetração tegumentar ocorre devido a uma ação mecânica e química (enzimática), e o processo completo de penetração leva aproximadamente 12 horas. A partir de 72 horas após a inoculação, o inseto encontra-se completamente colonizado pelo fungo. A morte do inseto ocorre devido à falta de nutrientes e ao acúmulo de substâncias tóxicas.
Os insetos colonizados tornam-se rígidos e cobertos por uma camada de micélio branco que posteriormente se transforma em conidióforos, uma camada pulverulenta de conídios capaz de contaminar outros insetos sadios presentes na área, ampliando a eficácia do controle biológico de pragas.
Aplicação
O produto pode ser aplicado através dos seguintes métodos:
Aplicações terrestres:
A aplicação deve ser realizada através de pulverizador costal, barra tratorizado ou turbo atomizador, calibrado para trabalhar com pressão e volume de calda constante. Devem ser equipados com pontas de pulverização que reduzam as perdas por deriva e promovam uma cobertura homogênea, conforme as recomendações do fabricante. Aplicar volume de calda de 80 a 300 L/ha. Para aplicações direcionadas ao solo, independente da cultura, indica-se que a aplicação seja realizada com o solo úmido ou, caso necessário, com leve irrigação após a aplicação do produto.
Aplicação aérea:
Para as aplicações foliares, utilizar aeronave agrícola equipada com pontas de pulverização ou atomizadores rotativos, que promovam uma cobertura homogênea, conforme as recomendações do fabricante. Aplicar volume de calda de 30 a 60 L/ha. Para esta modalidade de aplicação recomenda-se o uso do adjuvante Naft® na dose 50 a 100 mL/ha.
Aplicação via drone:
Para as aplicações foliares, utilizar drones de pulverização agrícola com pontas de pulverização ou atomizadores rotativos, que promovam uma cobertura homogênea, conforme as recomendações do fabricante. Aplicar volume de calda de no mínimo 10 L/ha. Para esta modalidade de aplicação recomenda-se o uso do adjuvante Naft® na dose 50 a 100 mL/ha.
Seguir as recomendações de tecnologia de aplicação fornecidas pelo agrônomo responsável.
Precauções gerais
Produto de uso exclusivamente agrícola. CATEGORIA 5 – PRODUTO IMPROVÁVEL DE CAUSAR DANO AGUDO. Consulte sempre um engenheiro agrônomo e siga corretamente as instruções recebidas. É importante optar pelo manejo integrado de praga. Leia o rótulo e faça-o a quem não souber ler. Para manusear o produto, utilize equipamentos de proteção individual especificados no rótulo e bula. As embalagens devem ser destinadas as unidades de recebimento do inpEV.

Produtos relacionados
Confira abaixo alguns produtos relacionados
Notícias
Confira nossas últimas publicações
Saber mais
03/11/2025 - Notícias da Imprensa
CONVITTIA reforça a estratégia da Vittia de proximidade e de escuta ativa do campo
Com o conceito “escutamos quem vive o agro todos os dias”, a iniciativa estreita..

27/10/2025 - Notícias da Imprensa
Vittia conquista o Prêmio Líderes do Agronegócio 2025 em Boas Práticas e Compliance
Ribeirão Preto (SP), outubro de 2025 – A Vittia, empresa 100% brasileira e referência..

13/08/2025 - Notícias da Imprensa
Vittia lança podcast para aproximar conhecimento técnico do dia a dia do campo!
“VitExpert ” estreia em formato digital e será apresentado mensalmente com foco em produtividade e..

04/06/2025 - Notícias da Imprensa
Triunfe® é o grande destaque da Vittia na 50ª Expocitros
Novo multissítio concentrado tem composição inédita à base de cobre e enxofre capazes de..

09/05/2025 - Sustentabilidade
O tomate na agricultura brasileira: desafios e oportunidades
O Brasil é um dos maiores produtores de tomate do mundo, com uma produção que ultrapassa..
Perguntas frequentes
Tire suas dúvidas sobre o uso e os benefícios dos nossos produtos.
O que é o Bovéria-Turbo® WP e para que serve?
Bovéria-Turbo® WP é um inseticida microbiológico formulado com o fungo Beauveria bassiana BVF15, uma cepa exclusiva da Vittia reconhecida por sua alta virulência e eficiência no controle de pragas como mosca-branca, cigarrinha-do-milho, bicudo-da-cana-de-açúcar e broca-do-café. É uma solução biológica segura e eficaz para diferentes culturas agrícolas.
O que significa a formulação WP (pó molhável)?
A sigla WP significa “Wettable Powder”, ou pó molhável. É uma formulação sólida, seca e estável que só se torna líquida e aplicável ao ser dispersa em água, formando uma suspensão para ser usada no processo de aplicação.
Por que a proteção contra raios UV é importante?
Os raios UV podem reduzir a viabilidade dos microrganismos aplicados na lavoura. A formulação do Bovéria-Turbo® WP protege os esporos dessa radiação, mantendo o fungo ativo por mais tempo e aumentando a eficiência do controle biológico.